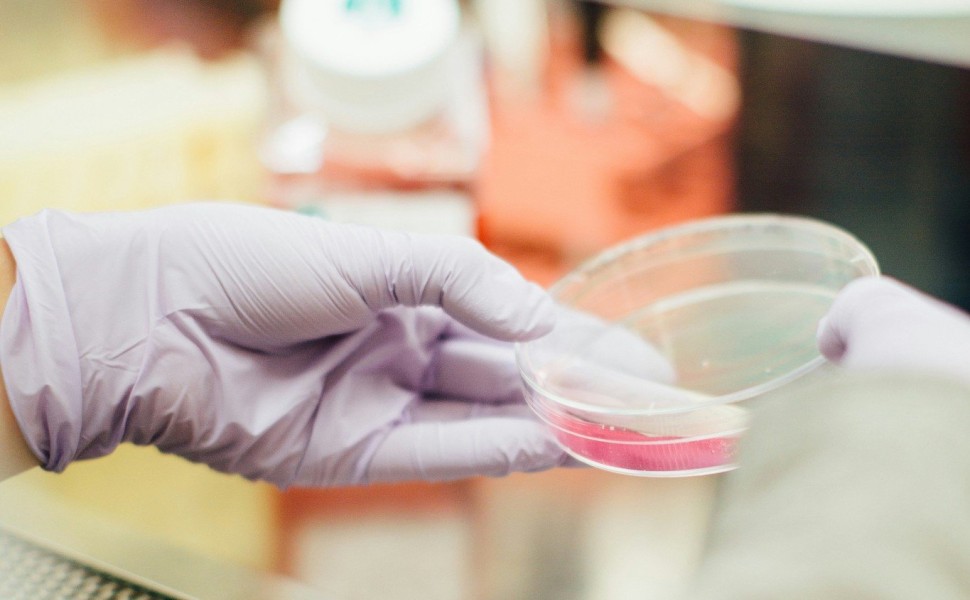

Πέρα από τη ζωή και τον θάνατο: Επιστήμονες δημιούργησαν μια «τρίτη κατάσταση» ύπαρξης
Ερευνητές απομόνωσαν κύτταρα που συμπεριφέρονται διαφορετικά από τον γενετικό τους προγραμματισμό και σχηματίζουν πολυκύτταρα όντα.
Σε μια νέα μελέτη που δημοσιεύεται στο περιοδικό Physiology, ερευνητές αναφέρουν ότι δερματικά κύτταρα από νεκρά έμβρυα βατράχου μπορούσαν να προσαρμοστούν στις συνθήκες του εργαστηρίου και να αναδιοργανωθούν σε πολυκύτταρους οργανισμούς που ονομάστηκαν xenobots.
Η εμφάνιση νέων πολυκύτταρων μορφών ζωής από κύτταρα νεκρών οργανισμών εισάγει μια «τρίτη κατάσταση» πέρα από τα όρια της ζωής και του θανάτου.
Οι οργανισμοί αυτοί παρουσιάζουν συμπεριφορές που υπερβαίνουν τους αρχικούς βιολογικούς τους ρόλους. Ειδικότερα, τα xenobots χρησιμοποιούν «κυτταρικές βλεφαρίδες» για να μετακινηθούν στο περιβάλλον τους, ενώ σε ένα ζωντανό έμβρυο οι βλεφαρίδες χρησιμοποιούνται για να μετακινούν βλέννες.
Τα xenobots είναι επίσης ικανά να αυτοαναπαραχθούν, δηλαδή να αντιγράψουν τη δομή και τη λειτουργία τους χωρίς να αυξηθούν. Αυτό διαφέρει από τη συνήθη αναπαραγωγή, που περιλαμβάνει αύξηση στο εσωτερικό του μητρικού οργανισμού. Οι ερευνητές βρήκαν επίσης ότι ανθρώπινα κύτταρα πνεύμονα μπορούν να αυτοοργανωθούν σχηματίζοντας πολυκύτταρους οργανισμούς που κινούνται. Αυτά τα anthrobots συμπεριφέρονται διαφορετικά. Όχι μόνο κινούνται, αλλά επιδιορθώνουν τους εαυτούς τους και τα νευρικά κύτταρα που τοποθετούνται δίπλα τους.
Τα ευρήματα αυτά αποδεικνύουν την εγγενή πλαστικότητα των κυτταρικών συστημάτων και αμφισβητούν την ιδέα ότι τα κύτταρα και οι οργανισμοί μπορούν να εξελιχθούν μόνο με προκαθορισμένους τρόπους. Η «τρίτη κατάσταση» υποδηλώνει ότι ο θάνατος του οργανισμού μπορεί να παίζει σημαντικό ρόλο στον τρόπο με τον οποίο η ζωή μετασχηματίζεται με την πάροδο του χρόνου.
«Η “τρίτη κατάσταση” αλλάζει τον τρόπο με τον οποίο οι επιστήμονες αντιλαμβάνονται την κυτταρική συμπεριφορά», λένε οι βιολόγοι Πίτερ Νομπλ και Άλεξ Πόζιτκοφ, που υπογράφουν τη μελέτη. «Υπάρχουν περιστάσεις όπου οι οργανισμοί αλλάζουν σε κάτι που δεν είναι προκαθορισμένο», συμπληρώνουν. Πρόκειται για κάτι διαφορετικό από τη μεταμόρφωση της κάμπιας σε πεταλούδα, που είναι μια γενετικά προκαθορισμένη διαδικασία. Και τα καρκινικά κύτταρα εξαιρούνται, γιατί δεν εμφανίζουν νέες λειτουργίες.
«Τα ευρήματα αποδεικνύουν την εγγενή πλαστικότητα των κυτταρικών συστημάτων και ανατρέπουν την πεποίθηση ότι τα κύτταρα και οι οργανισμοί εξελίσσονται με προκαθορισμένο τρόπο», λένε οι Νομπλ και Πόζιτκοφ. Η «τρίτη κατάσταση» υποδηλώνει ότι ο θάνατος παίζει σημαντικό ρόλο στο πώς έχει εξελιχθεί η ζωή.
Οι ιατρικές και φαρμακευτικές δυνατότητες μπορεί να αλλάξουν ριζικά το τοπίο. Τα anthrobots που μπορούν να δημιουργηθούν από τα κύτταρα ενός ασθενή είναι δυνατό να προγραμματιστούν ώστε να επιδιορθώσουν τραυματισμένα κύτταρα, να μεταφέρουν φάρμακα ή να εξαφανίσουν καρκινικούς όγκους.